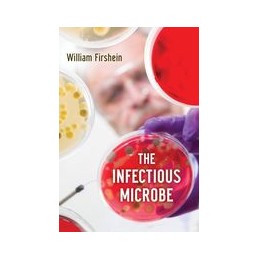
The Infectious Microbe

- W koszyku nie ma jeszcze produktów
- Wysyłka
- Razem 0,00 zł
- Medycyna
- Anatomia
- Anestezjologia i int. terapia
- Chemia ogólna i biochemia
- Chirurgia
- Choroby zakaźne
- Dermatologia i kosmetologia
- Diagnostyka laboratoryjna
- Diagnostyka obrazowa
- Dla kandydatów na AM
- Epidemiologia i zdr. publiczne
- Farmacja
- Farmakologia
- Fizjologia
- Genetyka
- Ginekologia i położnictwo
- Histologia z embriologią
- Immunologia
- Interna
- Języki obce
- L-DEK
- LEK
- Medycyna naturalna
- Medycyna paliatywna
- Medycyna pracy
- Medycyna ratunkowa
- Medycyna rodzinna
- Medycyna sądowa
- Medycyna sportowa
- Mikrobiologia
- Nauki pokrewne
- Neurologia
- Okulistyka
- Onkologia
- Organizacja opieki zdrow.
- Otorynolaryngologia
- Patofizjologia
- Patomorfologia
- Pediatria
- Pielegniarstwo
- Psychiatria
- Psychologia zdrowia
- Rehabilitacja i fizjoterapia
- Seksuologia
- Stomatologia
- Weterynaria
- Żywienie
- Zdrowie
- Alergie
- Badania lekarskie
- Ból
- Choroby jamy brzusznej
- Choroby kobiece
- Choroby mężczyzn
- Choroby neurologiczne
- Choroby oczu, uszu
- Choroby płuc
- Choroby psychiczne
- Choroby serca i naczyń
- Ciąża i poród
- Diety
- Dziecko
- Hormony
- Kości, stawy, mięśnie
- Leki
- Masaże, Gimnastyka, Rehabilitacja
- Medycyna naturalna (Zdrowie)
- Medycyna niekonwencjonalna
- Nadciśnienie, cukrzyca, cholesterol
- Neurobiologia
- Niepełnosprawność
- Nowotwory
- Poradniki, encyklopedie
- Seks
- Sen
- Skóra - choroby, pielęgnacja
- Sprawność fizyczna
- Uzależnienia
- Wstydliwe problemy
- Zęby
- Zwierzę w domu
- Psychologia
- Gerontologia
- Kinezjologia
- Metodologia i statystyka
- Neuropsychologia
- NLP
- Parapsychologia
- Pedagogika
- Poradniki psychologiczne
- Praca socjalna
- Praca z grupami
- Psychoanaliza
- Psychologia emocji i motywacji
- Psychologia kliniczna
- Psychologia konsumenta
- Psychologia ogólna
- Psychologia organizacji i zarządzania
- Psychologia osobowości i różnic indywidualnych
- Psychologia poznawcza
- Psychologia relacji
- Psychologia rodziny
- Psychologia rozwojowa
- Psychologia sądowa i penitencjarna
- Psychologia społeczna
- Psychologia wychowawcza
- Psychologia - pozostałe
- Psychopatologia
- Psychoterapia
- Socjologia
- Uzależnienia
- Zagraniczne
- Allied Health Services All
- Allied Sciences
- Anatomy
- Anesthesiology
- Audiology & Speech Pathology
- Biochemistry
- Biostatistics
- Clinical Medicine
- Clinical Psychology
- Complementary Therapies
- Cosmetology
- Dentistry
- Dermatology
- Diagnostic Imaging
- Dictionaries & Terminology
- Diet Therapy
- Drug Guides
- Embryology
- Emergency Medicine
- Epidemiology
- Exams
- Family Practice
- Forensic Medicine
- Genetics
- Gynecology
- Health & Fitness
- Health Information Management
- Histology
- Human Nutrition
- Immunology
- Infectious Diseases
- Intensive Care
- Internal Medicine
- Laboratory Medicine
- Medical Administration
- Microbiology
- Neurology
- Nursing
- Nursing / Anesthesia
- Nursing / Assessment & Diagnosis
- Nursing / Critical & Intensive Care
- Nursing / Emergency
- Nursing / Fundamentals & Skills
- Nursing / Gerontology
- Nursing / Home & Community Care
- Nursing / Issues
- Nursing / LPN & LVN
- Nursing / Management & Leadership
- Nursing / Maternity, Perinatal, Women's Health
- Nursing / Medical & Surgical
- Nursing / Nurse & Patient
- Nursing / Nutrition
- Nursing / Oncology & Cancer
- Nursing / Pediatric & Neonatal
- Nursing / Pharmacology
- Nursing / Psychiatric
- Nursing / Reference
- Nursing / Research & Theory
- Nursing / Test Preparation & Review
- Nursing Home Care
- Occupational Health
- Oncology
- Ophthalmology
- Otorhinolaryngology
- Paliative medicine
- Pathology
- Pathophysiology
- Pediatrics
- Perinatology and Neonatology
- Pharmacology
- Pharmacy
- Physiology
- Podiatry
- Preventive Medicine
- Psychiatry
- Radiological and Ultrasound Technology
- Radiology
- Rehabilitation
- Research
- Sexuology
- Sleep Medicine
- Sports Medicine
- Surgery
- Veterinary
- Nowości
- Zapowiedzi
- Nowy dzial
Lista książek od wydawcy OUP USA
Indeks: 87286
Parenting and Teen Drug Use
Autor: Lawrence M. Scheier
The Most Recent Findings from Research, Prevention, and Treatment
Indeks: 87285
Safe Passage
Autor: Mark Lazenby
A Global Spiritual Sourcebook for Care at the End of Life
Indeks: 87303
Anxiety and Related Disorders Interview Schedule for DSM-5 (ADIS-5) - Adult and Lifetime Version
Autor: David H. Barlow
Clinician Manual
Indeks: 87301
Anxiety and Related Disorders Interview Schedule for DSM-5 (ADIS-5) - Adult Version
Autor: David H. Barlow
Client Interview Schedule 5-Copy Set
Indeks: 87302
Anxiety and Related Disorders Interview Schedule for DSM-5 (ADIS-5) - Lifetime Version
Autor: David H. Barlow
Client Interview Schedule 5-Copy Set